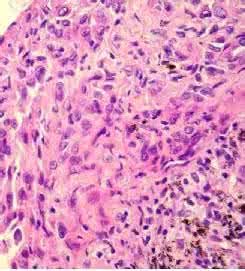
上皮樣細胞

基本內容
肉芽腫的主要細胞成分。
感染性肉芽腫引起機體免疫反應,特別是細胞免疫反應,使巨噬細胞轉變成上皮樣細胞和多核巨細胞。上皮樣細胞鏡下細胞質呈粉紅色,略呈顆粒狀,細胞質界限不清,細胞核呈圓形或長圓形,有時核膜摺疊,染色淺淡,核內有1~2個核仁。
上皮樣細胞是一種幹細胞,可行細胞分裂產生兩個完全相同的細胞。而後,子細胞經由不對稱的細胞分裂,產生一個與親代相同的細胞及另一個非幹細胞的先去細胞或神經元。含有較多的脂酶,由圓形或輕度梭形的組織細胞,吞噬消化含有蠟質膜的結核菌時演變而成。
臨床表現:
多見於青年人掌或指屈面、前臂和足部,也可見於肢體近端或更深部組織,罕見於臀部或陰莖,
結節為單個或多發,位於皮內或皮下,生長緩慢,切除後易復發,發生於四肢近側的結節常沿筋腱膜面
或血管、神經呈縱向隱性發展,淺表結節早期即可破潰,沿前臂發生的結節常形成多發潰瘍或
融合成環狀斑塊,局部切除後 85% 復發,早期可見淋巴結轉移,晚期多轉移至肺部。
上皮樣細胞
上皮樣細胞